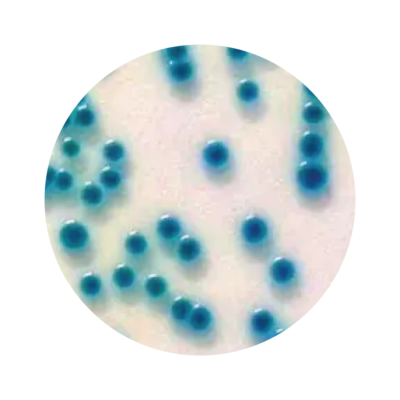
Rapid-S

RAPID’ Sakazakii Medium
Overview
At Brennan & Co we’re proud to partner with Bio-Rad to deliver the product and support you need, enabling you to meet food microbiology laboratories regulatory standards.
Key Benefits
- Easy-to-read chromogenic reaction Blue to blue-green colonies
- Cost-effective short protocol
- No selective enrichment in mLST + Vancomycin
- Negative results in less than 42 hr
- Validation
- Certified NF VALIDATION according to the ISO 16140:2003 standard for the detection of Cronobacterspp. in infant milk powders
Principle
Detection is based on a specific enzymatic activity common to all species of Cronobacter. Hydrolysis of the chromogenic substrate 5-bromo-4-chloro-3-indol α-D-glucopyranoside leads to the formation of typical turquoise-colored colonies.
The medium includes compounds carefully selected to promote the growth of Cronobacter spp. while suppressing interfering flora, giving the medium increased selectivity. Competing bacteria, if not completely inhibited, will form light purple or gray colonies.

When purchasing Bio-Rad Products through Brennan & Co, you’ll also benefit from:
- Working with a more personal supplier (We aren’t catalogue based & we don’t box ship).
- Unrivalled technical support
- Scientific advice based on expertise and our own research experience
- A flexible & dynamic approach to identifying the best suited solutions for our customers
- Direct Shipping from Dublin which means short delivery times within the island of Ireland
Product Specialists that Go The Extra Mile – Aaron Mullins
At Brennan & Co, we’re extremely proud to have some of the most hard working life science Product Specialists in the country as part of our team. Aaron Mullins, (pictured across) has expertise and experience with using the food & dairy products that Brennan & Co provide. He’s also got a passion for getting our customers the right product for them. At Brennan & Co we know how important it is, to make the right choice when it comes to products around testing and food quality. That’s why our Product Specialists will be there for you, every step of the way.
Have you got a question?
We’d love to hear from you.

We’re here for you.
At Brennan & Co our Life Science division is passionate about providing quality products to the Life Sciences industry and it’s professionals. Our team work hard to get you the products you need when you need them. We want empower you to do the best work you can, through stellar products and after sales care that really cares.